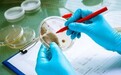
新闻晚报:卫健委决定增加抗原检测 吉林农业科技学院6556名学生全部转运

【国家卫健委:在核酸检测基础上增加抗原检测 居民可自购试剂自测】据国家卫健委,经研究,国务院应对新型冠状病毒肺炎疫情联防联控机制综合组决定在核酸检测基础上,增加抗原检测作为补充,并组织制定了《新冠病毒抗原检测应用方案(试行)》。《方案》规定了抗原检测的适用人群:一是到基层医疗卫生机构就诊,伴有呼吸道、发热等症状且出现症状5天以内的人员;二是隔离观察人员,包括居家隔离观察、密接和次密接、入境隔离观察、封控区和管控区内的人员;三是有抗原自我检测需求的社区居民。同时,明确了3类人群进行抗原检测需满足的主要条件、检测试剂的获得渠道,制定了检测发现阳性后的处置管理流程,促进抗原检测与核酸检测相衔接。为便于各地规范开展检测,《方案》还包括2个附件,即基层医疗卫生机构新冠病毒抗原检测基本要求及流程、新冠病毒抗原自测基本要求及流程。(国家卫健委)>>详情
【300台大巴车支援 吉林农业科技学院学生全部转运】昨日午夜,吉林农业科技学院密接、次密接学生转运工作仍在进行。大巴车经消杀后进入学校,学生排队上车。学生全部转运学校清空后,吉林农业科技学院将进行全面消杀。截至今日8时5分,吉林农业科技学院共转运学生6556人,85名带队老师随车转运,实现学生全部转运。其中:转运至吉林市607人,其余6034人分别转运至辽源市、长白山、白城市、白山市、通化市、松原市。现场工作人员介绍,此次从省内各地调运了近300台大巴车支援。(央视新闻)
【吉林省本轮疫情累计确诊526例 为奥密克戎变异株BA.2进化分支】通过病毒全基因组测序分析,本次吉林省内疫情病毒株为奥密克戎变异株BA.2进化分支。结合基因组测序和前期报告感染者的流行病学调查情况分析,初步判断此次疫情为2月下旬输入吉林省并在本地传播。
截至3月11日13时,本次疫情全省累计报告新冠肺炎确诊病例526例,其中吉林市396例、长春市78例、延边州51例、松原市1例;全省累计报告无症状感染者590例,其中吉林市428例、长春市120例、延边州33例、梅河口市5例、四平市2例、辽源市和松原市各1例。(央视新闻)
【长春:全市小区单位封闭式管理,每户每2天1人外出采购】11日,长春市疫情防控指挥部发布最新通知,其中提到:停止一切非必要流动。全市小区(村)、单位实行封闭式管理。每户家庭每2天由1人外出采购必要的生活物资,有特殊出入需求的居民,由社区(村)从严管控,上述两类人员需持证出入,出入证由所在社区(村)开具。公安干警、医护人员等其他必要的流动人员,需持相关证件或疫情防控指挥部开具的证明出入。(长春市疫情防控指挥部)>>详情
【青岛莱西本轮疫情累计报告413例确诊 其中学校师生超300人】3月11日16:30,青岛市召开疫情防控新闻发布会,通报疫情防控最新进展。3月10日12时至3月11日12时,莱西疫情新增109例本土新冠肺炎确诊病例(其中有8例为无症状感染者 转为确诊病例)、264 例无症状感染者。自3月4日莱西疫情发生以来,截至3月11日12时,莱西疫情累计报告确诊病例413例、无症状感染者728例。确诊病例中,学生279例、教师37例、重点人群97例。(半岛都市报)
【农业农村部发起全国大豆高产竞赛】日前,农业农村部在全国范围内发起大豆高产竞赛,推动打造一批高产百亩方千亩片、推介一批新品种、集成一批高产新技术新模式、挖掘一批种植能手和高产典型,力争将专家产量转化为农户产量、典型产量转化为大田产量,辐射带动全国大面积均衡增产。
目前我国大豆平均亩产仅为世界平均水平的70%,比美国等主产国低100公斤左右。近年来,我国大豆小面积攻关亩产突破330公斤,涌现出了一批高产典型。从国内国外看,我国大豆单产提升潜力较大,是今后提高我国大豆产能的重要途径。(农业农村部)>>详情
【韩当选总统会见中国驻韩大使 称坚信韩中关系将再上新台阶】3月11日,中国驻韩国大使邢海明会见韩国当选总统尹锡悦,转交习近平主席贺电,并就中韩关系发展等交换了意见。
据中国驻韩国大使馆11日消息,邢海明转交贺电后表示,中韩两国是密不可分的友好近邻和重要战略合作伙伴。建交以来,在两国元首引领和两国政府、人民共同努力下,中韩关系取得了全方位跨越式发展,给两国人民带来了实实在在的利益,也为促进地区及世界和平稳定与发展繁荣作出了积极贡献。今年是中韩建交30周年,两国关系面临提质升级重要机遇,中方愿同韩方基于相互尊重、平等互利原则继续推动双边各领域交流合作深化发展。相信在两国元首战略引领下,中韩关系将在未来5年、30年取得新的更大发展,更好地造福两国和两国人民。(中国驻韩国大使馆)
【中国航空装备出口里程碑!6架歼10CE交付巴基斯坦】当地时间3月11日,巴基斯坦空军在卡姆拉举行首批6架歼10CE接装仪式。巴基斯坦总理伊姆兰·汗出席仪式。这标志着中国新一代航空主战装备已正式列装巴基斯坦空军,实现了中国新一代航空主战装备成体系、成建制出口,是中国航空高新装备出口的又一重要里程碑。(航空工业)
【中国互联网遭受境外网络攻击 攻击地址主要来自美国】国家互联网应急中心监测发现,2月下旬以来,我国互联网持续遭受境外网络攻击,境外组织通过攻击控制我境内计算机,进而对俄罗斯、乌克兰、白俄罗斯进行网络攻击。
经分析,这些攻击地址主要来自美国,仅来自纽约州的攻击地址就有10余个,攻击流量峰值达36Gbps,87%的攻击目标是俄罗斯,也有少量攻击地址来自德国、荷兰等国家。
据悉,国家互联网应急中心已及时对以上攻击行为最大限度予以处置。(新华社)
【两年间最高级别官方会见 中国驻澳大使会见澳外长】据中国驻澳大利亚大使馆网站3月10日消息,3月9日,肖千大使在悉尼会见澳大利亚外长佩恩。对此,《悉尼先驱晨报》等澳媒10日也进行了报道。
报道指出,此番澳大利亚政府部长级官员会见新到任的中国驻澳大使,是两国之间几年来最高级别的对话接触,但双方未能解决任何悬而未决的分歧。(观察者网)>>详情
【卫星图像曝光俄军64公里长车队现状】据美国有线电视新闻网(CNN)报道, 随着乌克兰首都基辅周围的云层暂时散去,美国Maxar Technologies公司透露,3月10日早些时候拍摄的新卫星图像显示,在基辅西北部延伸超64公里的俄罗斯军车车队已经“基本上分散和重新部署”。(天下事)
【乌军曝光最新作战画面 装备大量西方反坦克武器】乌克兰自由电台3月10日发布乌军最新的作战画面,一小队乌军士兵在基辅郊外与俄军爆发激烈战斗。
从视频中可以看出乌军装备了大量西方援助的武器装备,包括德国的铁拳反坦克榴弹发射器、瑞典的AT4反坦克火箭筒以及英国的NLAW单兵反坦克导弹。(天下事)
【俄国防部:已使3213处乌克兰军事基础设施瘫痪】根据俄罗斯国防部今天发布的最新战报,自特别军事行动开始以来,俄军已使3213处乌克兰军事基础设施瘫痪。其中包括98架飞机、118架无人机、1041辆坦克和装甲车、113台多管火箭炮、389门火炮和迫击炮、843辆特种军用车辆等。(财联社)
【外媒:英国宣布对386名俄国家杜马议员实施制裁】英国外交部发表声明称,对俄罗斯国家杜马(下议院)386名议员实施制裁,理由是这些议员曾投票支持顿涅茨克和卢甘斯克“独立”。英国《卫报》报道称,俄罗斯国家杜马上个月批准了关于承认顿涅茨克和卢甘斯克“独立”的条约。英国外交部11日在声明中称,被制裁的议员将被禁止前往英国、获得在英境内的资产以及禁止在英国经商。(环球网)
【美国与罗马尼亚和爱沙尼亚举行军演】当地时间10日,美国分别与乌克兰的邻国罗马尼亚以及波罗的海国家爱沙尼亚举行联合军事演习。罗马尼亚和爱沙尼亚同为北约成员国,还分别与乌克兰和俄罗斯接壤。其中,美国与罗马尼亚的联合军演从3月2日开始,一直持续至10日,双方共有大约900名士兵参演。罗马尼亚国防部在一份声明中表示,此次军演旨在加强北约成员国之间武装力量的“相互了解和相互协作”。(央视新闻)
【北约将举行年度最大军演:27国30000士兵参加 英国航母出动】当地时间14日,北约本年度最大规模军演“寒冷反应2022”将在挪威正式举行,将有来自27个国家的共3万名士兵参加此次防御性演习。
两年举行一次的北约“寒冷反应”军演9日已开始部分演习,14日将全面展开,为期1个月。陆上军演主要在挪威北部进行,大规模海上军演会在挪威海域附近进行。3万名参演士兵中1.4万人为陆军,8000人为海军,另外8000人为空军和参谋军官。
英国皇家海军威尔士亲王号航空母舰也将参加此次军演,这是该舰首次前往北极地区参加军演。挪威国家广播公司援引挪威军方报道称,此次演习是一场防御演习。(海外网)
“特别声明:以上作品内容(包括在内的视频、图片或音频)为凤凰网旗下自媒体平台“大风号”用户上传并发布,本平台仅提供信息存储空间服务。
Notice: The content above (including the videos, pictures and audios if any) is uploaded and posted by the user of Dafeng Hao, which is a social media platform and merely provides information storage space services.”